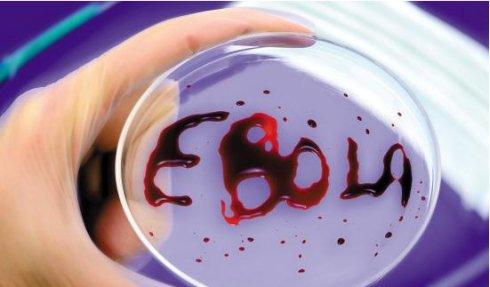
1410424872104339.jpg u=2844689130,731843241&fm=11&gp=0.jpg

|
中新社联合国9月9日电 (记者 李洋)世界卫生组织9日发布埃博拉疫情最新通报说,疫情已经造成近2300人丧生。联合国秘书长潘基文计划在即将于本月开始举行的新一届联大期间紧急召集有关应对埃博拉疫情的高级别会议。 世卫组织的数据显示,在几内亚、利比里亚、塞拉利昂和尼日利亚等国肆虐的埃博拉疫情已经造成至少2296人死亡,病例数达到4293例。 世卫称,上述有关病例统计未将利比里亚的新增病例列入。世卫称利比里亚的疫情面临大幅蔓延扩散,未来三周可能会新增数千病例。 世卫官员透露,用传统治疗措施已经难以控制埃博拉疫情在利比里亚的蔓延。在利比里亚的埃博拉病毒治疗机构已经人满为患,而这些机构无法应对更多患者。 世卫组织大流行病和流行病司长布里安德9日承认疫情病例数统计目前被低估,世卫正在设法提高统计准确率,努力确保患病者都被计入统计之中。 联合国秘书长发言人9日说,潘基文在同美国总统奥巴马通电话时透露了召集高级别会议的想法,他表示希望政府和非政府组织代表以及专家学者等都能通过这次会议更加积极应对疫情。 国际社会已经加强对埃博拉疫情的防控力度,美欧都承诺要对西非有关国家加大援助,中方也表示将帮助塞拉利昂建立埃博拉病毒检测实验室。 |
首页推荐
医患直通车
名家在线
读者会
活动及投票
招聘专栏
非洲埃博拉疫情已致近2300人丧生
时间:2014-09-11 16:39来源:未知 作者:admin 点击:
次
中新社 联合国 9月9日电 (记者 李洋)世界卫生组织9日发布埃博拉疫情最新通报说,疫情已经造成近2300人丧生。联合国秘书长潘基文计划在即将于本月开始举行的新一届联大期间紧急召集
------分隔线----------------------------
- 发表评论
-
- 最新评论 进入详细评论页>>
- 栏目列表
-